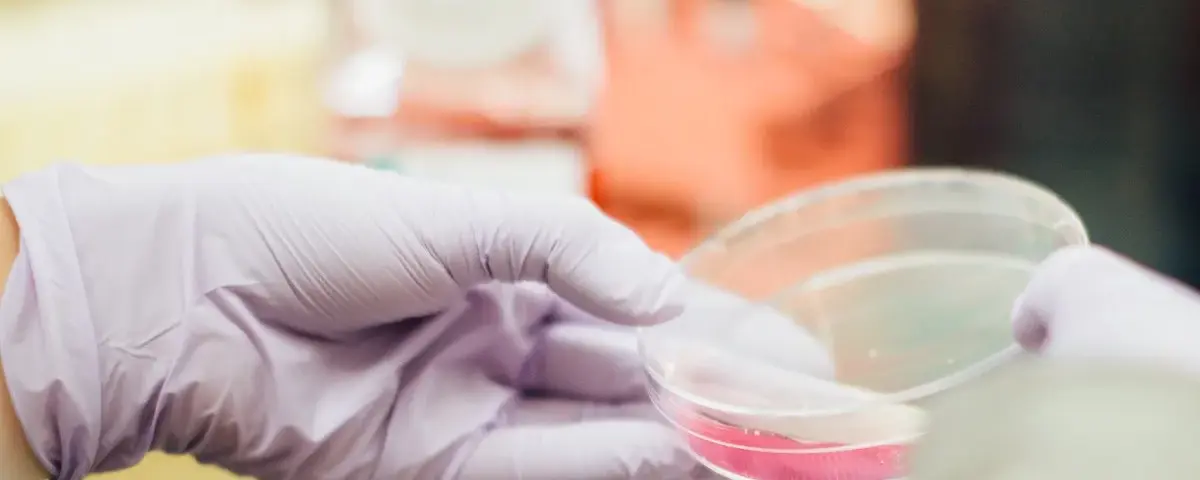
fashion product testing

E68: How to Be the Best Fashion CEO for Your Brand

Just because you started your brand and it is your “baby” doesn’t mean that you know or have the skills to grow it and make it profitable. And unless it is profitable and operated in a way that allows it to grow – you will be stuck in a hamster wheel feeling exhausted and frustrated. […]
E67: Do something different to sell more with Jane Hamill

Jane Hamill, a successful ex-clothing designer and retailer who saw a growing need in this niche for honest advice and specific step-by-step strategies to run a profitable product business without losing your shirt – or your mind. In this episode, we chat about the need to do something different to sell more as well as […]
E66: Why is my fashion brand not selling?

If you have a fashion brand chances are at some point or right now you might be wondering why you are not selling – at all or more of your products. It is very common for new brands to launch and sell nothing for a long time. Imagine having spent months and years working on […]
Lessons Learned from Launching a Fashion Fine Jewellery Brand

If you want to discover what invaluable lessons I learned from launching a fashion fine jewellery brand, then read on. It is often said that hindsight is 20/20 and in the case of launching and growing fashion business, this most certainly is the case. When you are fresh and new to an industry it is […]
E65: Three Lessons Learned from Launching & Growing a Fine Jewellery Brand

Back in 2008 I launched my very own fine jewellery brand Deci London. Despite knowing so much after working for 10+ years in the fashion industry, launching and growing a brand and business of my own came with a whole new set of learning and lessons I didn’t expect. Reflecting back on running the brand […]
E64: Do What You Love with Anne-Claude from MonPanama

A childhood love for hats became a thriving business for Swiss-born, Thailand based Anne-Claude, the founder of accessories resort brand Mon Panama. When the pandemic came, the demand for her retail business overnight dried up. But closing down never crossed her mind. Her passion and determination to save her “business child” led her to pivot […]
E63: From Fast Fashion to Slow Circular Brand Building with Monika The Label

Meet Monika Young, a London-based creative, ex-fast fashion buyer and a lover of all things California. When her buying job in Berlin started giving her the blues, she knew she had to make a change. She saw first-hand how fast fashion brands were destroying the planet and she wasn’t down for being part of the […]
E62: Branding vs Direct Response Fashion Business Growth – What is Best?

Most fashion brand founders chase cash in the wrong way and for the wrong reasons. Often if they find financial success at the beginning, they struggle to maintain it and make it last. Others spend years building a “brand” without (seemingly) much success until one day…everything seems to fall into place and money starts to […]
E61: Craft is Sanity and Brand is Vanity with Yusuf Osman

Yusuf’s passion for making started whilst reading law at The London School of Economics where he thrived in the extracurricular. He continued to explore his creative side whilst training to be a solicitor. An avid workshop taker, he tried the gamut of crafts and discovered a passion for premium natural materials and a flair for […]
E60: Growing Your Brand Via Hybrid Collection Co-creation

Most creative brand founders inexperienced in business observe and emulate how others do it. However, so much can be missed and left invisible to a trained eye. In this episode, you’ll discover how to add to your collection range strategically and by taking a lesser risk. Growth can come from many sources and not everything […]
E59: The right fashion collection can attract the right paying customers.

Have you seen a skyscraper built on top of a cluster of smaller houses and buildings? No, right? Not possible of course – we all know that. So why are so many creative and fashion brand founders expecting to build and grow a financially successful business based on poorly laid foundations? You may or may […]
E58: Having Cohesive Fashion Collections Can Grow Your Brand (Part 1)

Most creative brand founders and designers overestimate the importance of individual products and design elements and hugely underestimate the importance of having cohesive fashion collections. In fact – most creative brand founders do not understand what “cohesive” means in terms of a fashion collection structure. Listen to this episode and discover: The three key areas […]
057: Growing Your Brand Through Omni Sales Opportunities with Sonia Summan

Meet Sonia Summan – a multi-talented fashion industry expert who has spent 20+ years specialising in sales for a wide range of brands from the high street to the luxury segment of the industry. Quite honestly – there is nothing Sonia doesn’t know about growing a fashion brand vis a vis different routes to market. […]
E56: Struggling to grow your fashion brand? Here’s why…

More than half of those brands that launch close doors within a year or two of launch. Many struggle a little longer and join the long list of brands that once had so much promise and then they no longer could be sustained. If you wonder why or feel like you are one of those […]
E55: How a self-taught artist became a designer for Hermes with Arlette Ess

Meet Arlette Ess – a self-taught artist and ex-model who turned her art into wearable creations. And not only that…her works of art can now be bought at Hermes – the luxury brand that exemplifies art, craft and luxury. Listen to this episode and discover: How Arlette got her start in the fashion industry Why […]
E54: Great Fashion Brand Founders Ask Great Questions

The great creative brand founders, leaders and fashion business CEOs ask the best questions in order to get the right information. This is what ultimately distinguishes those who succeed from those who flounder and disappear. To find the right people to work with or hire and generally speaking great decisions are made as a result […]
E53: The importance of creative collaborations in business

Following on from the last episode setting out business trends to be mindful of throughout 2022, in this episode Dessy speaks to Karolina Barnes about the importance of creative collaborations as a growth business strategy. Episode notes: Listen to the episode and discover … Why this year all brands will have to reinvent themselves Why […]
E52: A preview of 2022 fashion industry’s core themes to pay attention to.

As we turn the leaf to a new year – what can we expect from a year that follows on from an already very challenging past couple of years? In this episode, Dessy discussed five core themes she believes are important to take note of and be mindful of as the new year unfolds. Episode […]
051: 3 Reasons Why It‘s Important To Have a Niche In Your Fashion Business

To niche or not to niche is the question most ambitious fashion would be fashion-preneurs and brand founders should ask themselves but oftentimes don’t. The result is often struggling to find success, frustration and loss of time and money. In this episode, you will discover why less is more when it comes to launching a […]
Why using leftover fabric is good for the fashion industry

Leftover fabric, deadstock materials, surplus stock…these are words that a decade ago were not part of the fashion vocabulary. If you had included them in a fashion conversation, you would have raised eyebrows. Yet today, they are as much part of the vernacular as any other fashion term. It is no wonder that fashion is […]
Vegan Leather vs Real Animal Leather: the race towards sustainable fashion

Vegan Leather or Real Animal Leather? Sustainability and making fashion more responsible and better for the planet have been on the global environmental agenda for a number of years now. The current pandemic has magnified the issue even more and made creative entrepreneurs and consumers alike be more conscientious about their daily choices. According to […]
Think globally but manufacture fashion locally

What a phenomenal time to be alive. There has been no other time in the history of humankind when so much has changed in such a short period of time. When the opportunities we have, outnumber the obstacles we face. [The original version of this article was first published at Estila magazine Vol 12 / […]
Interview with Dessy: What is the future of the fashion industry?

While we are going through these unprecedented times caused by Covid-19, many fashion start-ups and independent fashion brands might be thinking about how the industry will change and what the future of the fashion industry be in future. > This interview was published at Estila Magazine < Today I’m talking to Dessy Tsolova from Fashion Insiders […]
9 Effective Ways to Launch and Grow a Fashion Brand Online

To launch and grow a fashion brand online seems like a glamorous way to make a living. Fashionistas and those with an eye for style would be perfect for this job. Unfortunately, there’s more to selling stylish clothes, shoes, and accessories in today’s overcrowded online space. Most businesses usually start small. To launch and grow […]
The 9 C’s vital to how to grow a fashion brand in 2020

Knowing how to grow a fashion brand is always useful, least of all because it can be very costly. I often say that launching and growing a fashion business is akin to throwing money into a black hole. You always need to put in more and the returns are rarely apparent and immediate. But in […]
10 Top Signs You’re Working with the Wrong Manufacturer

Fashion manufacturing is not for the faint-hearted. Working with the wrong manufacturer can be painful. Fashion manufacturing is like relationships. In fact, it is apt to compare the process to dating…Pick the right fashion factory – and you’ll live happily ever after. Pick the wrong one – and life will not be worth living. Regardless […]
Sustainable Fashion Terminology Explained

Sustainable fashion terminology can be confusing to most. Like many other industries, fashion is shaped by economic and political forces. It is like a living organism – always evolving and changing. I’m sure – like me – you must find it hard to keep up with all the terminology used by industry insiders. Not only […]
The Global Rise of Cruelty-Free Fashion

The rise of cruelty-free fashion and beauty brands is apparent and all around us. Over the last few years, keen followers of fashion, no doubt would have noticed a sharp increase in consumers seeking more conscious fashion choices. For many, the search led them to nowhere. Others chose to do something it and launched their […]
How to Clear Excess Stock and the Importance of It to Your Fashion Brand

In product-based businesses, the issue of excess stock is often a problem that is overlooked. It is, in fact, one of the silent killers known to the fashion business. Being aware of it and actively managing “it” is imperative for the health of any fashion business. Keeping it as low as possible is the ultimate […]
Ethical Kind Organic Peace Silk – Not Just Another Fashion Brand

True entrepreneurs are often driven by a resilient sense of mission. They don’t start businesses out of a desire, but out of need and want to change the world in their own small or large way. More and more lately we see such social entrepreneurs appear in the fashion industry. They launch fashion brands as […]
9 easy ideas to increase sales for your fashion brand

Many fashion brand owners and entrepreneurs I speak to often complain about lack of sales and ask “how do you increase sales for your fashion brand”? They blame the economy, social media and everything under the sun. Their brands and businesses suffer, struggle and often close because of no sales. The reality is somewhat different. […]
The Secret Sauce to a Successful Cohesive Fashion Collection

Designing a fashion collection is relatively easy. Anyone can do it. But creating and putting together a cohesive fashion collection that sells requires you to know the secret sauce. Say YES if you want to know the secret ingredients? Because we live in an age where we all want the recipe and a step by […]
The Top Seven Fashion Pricing Strategy Mistakes Brands Must Avoid

Fashion pricing strategy is one of the most challenging areas for fashion apparel and accessories brands. For the most part, the challenge is due to product (SKU) complexity, relatively limited item comparability within (especially small) brands and frequent flow of new collections. Pricing fashion products historically has involved more art than science. Being that most […]
Points of Measure: Helping Fashion Startups Succeed

Graduating with both a degree in Accounting and Apparel Design, it is no wonder that Natalie Smith married her love for exactness and passion for fashion and creativity. “Points of Measure” was the result of these converging interests. An online fashion education platform, helping fashion startups how to DIY, and just overall lending support and […]
How to Build Fashion Brand Trust Faster

In today’s oversaturated market, to build fashion brand trust, stand out and build or create a loyal following is not so easy. Not impossible, but not easy compared to even a few short years back even. For any business to survive not only do you need to have a good product that fills the hole […]
How to Infuse “Know, Like, Trust” Factor Into Your Fashion Brand

Infusing your fashion brand with Know Like Trust factor is incredibly important in today’s oversaturated designer fashion market. Or any industry for that matter. Gone are the days when, if you served your customers nicely, helped them over the phone or didn’t make a fuss when they returned something they stayed loyal and came time […]
Wenlin Studio: Empowering Communities Through Pursuit of Beauty

Gul E Raana is the founder and creative force behind the hand embroidery London based brand – Wenlin Studio. Though only a couple of years old, the brand has a clear mission that resonates with their growing loyal clientele – to create ethical and responsible fashion products while empowering small communities of artisans. As big […]
How to Launch Your Fashion Brand According to Your Niche (Part 3)

To launch a fashion brand to a specific niche of customers or market is an age-old tested recipe for business success. To grow your fashion brand is a whole other story. In this final instalment of our 3 part series, we show you how to do it and why it is important in fashion to […]
How to Launch Your Fashion Brand According to Your Niche (Part 2)

To launch a fashion brand to a specific niche of customers or market is an age-old tested recipe for business success. In these 3 part series, we show you how to do it and why it is important in fashion to follow and apply what already is proven to work well. In part 1 of […]
How to Launch Your Fashion Brand According to Your Niche (Part I)

When starting a fashion business, much like starting any business, there are some rules that apply and are there for a reason. Rule number one is to know your niche. That knowledge is the foundation for any successful business (be it a product or service-based) because it has an influence over every aspect of the […]
The Challenge Western Brands Face in Working with Clothing Manufacturers Overseas

Working with clothing manufacturers overseas is a natural progression for many fashion brands. The move is often necessitated by two main factors – a need for larger volume production or a necessity to reduce costs and increase margins. Finding clothing manufacturers overseas or any fashion manufacturers for that matter has got easier over the last […]
When to Look For a Manufacturer – Before or After Crowdfunding Campaign ?

QUESTION: When should I look for a manufacturer – before or after the Kickstarter crowdfunding campaign I plan to do, to raise funds, to launch my business? Astrid, Oslo (Norway) Hey Astrid, great question! Launching via a Kickstarter type of crowdfunding campaign is a great new way to leverage the power of the […]
7 Mistakes Career Changers in Fashion Industry Make

The fashion industry is like no other. To those on the outside – it is a glamorous and glitzy industry that looks fun and promises fame and riches. The truth is far from it. Yet there is no shortage of career changers willing and wanting to try their luck in it. Where those who hadn’t […]
Top 5 Reasons Why Not to Discount Your Fashion Brand Products

The 2008 global recession has a lot to answer for. Aside from so many fashion brands and retailers closing doors and filing for bankruptcy, many barely survived by adopting a discounting strategy and reducing their stock inventory by heavily reducing the retail price of their products. The discounting strategy fiasco wasn’t a one-off. It lasted […]
5 Ways Startups Can Use Tech Packs to Cut Costs and Save Time

Tech packs! Love them or hate them, if you’re in fashion – you simply need them! Like anything in life, the quality of the outcome depends on the quality of the input. In fashion, this is truer than in most other industries. Without a proper brief, a visual and verbal accurate communication, the end result […]
Why do so many fashion brands fail?

For an industry as dynamic and fast-paced as fashion, why do so many fashion brands fail? A topic that’s covered more and more of late, in the wake of so many retail stalwarts and iconic fashion brands filing for bankruptcy. The fashion industry is famous for its smoke and mirror image. Things are never how […]
How to Grow your Fashion Business by Stepping Outside the Box

To grow your fashion business you need to not only be visually creative but also be creative with how you conduct business, your strategy, marketing and all aspects that cumulatively contribute to the success of a business. Following “tried and tested” methodology is no longer a guarantee for success. So what now then? Too many […]
The Rise of Ethical Fashion Manufacturing

The terms “ethical (fashion) manufacturing” and “sustainability” have become the buzz words of our generation. But are they just a marketing gimmick or do brands and customers really care about the issues? One of the many great things about the internet era we live in is access to information. Everything and anything, 24/7. It is […]
6 Most Widely Used Garment Printing Techniques

Were you aware that there are six, yes six popular methods presently used to transfer coloured patterns onto cloth? No, neither did I. With so many different available options, it is useful to know what is the best method for different projects, and why are some methods so much more expensive than others? Let’s dive […]
9 Tips for Planning a Fashion Photoshoot

To plan a fashion photoshoot is incredibly time-consuming and setting aside weeks, and even months, to arrange everything is quite common. The more time you give yourself, the less stressful the experience. Once your samples have been produced and have passed all of the fit and quality tests, selling your range and marketing will, no […]
Solo Entrepreneurship – the Good, the Bad and the Ugly.

Starting a business on one’s own is never easy. But starting one in the fashion arena is a particularly steep hill to climb, full of lessons and paved with expensive mistakes. After a long and successful corporate career, Hema Selvaraj decided to do just that – launch a jewellery brand. Here she takes a look […]
How to size label your clothing range – letters vs numbers

Selecting the correct size label for your clothing range and whether you use letters or numbers sends a clear message about the market you aim to enter. Their use isn’t based on random selection. Both letters and numbers are used to communicate very different things in the industry. In regards to sampling size selection, this […]
What is a Technical Drawing in Fashion Design?

Providing factories with a “Technical Drawing” otherwise known as a “Flat Drawing” is one of the essential requirements when manufacturing garments or accessories. Whether you are a designer who has skills in fashion sketching, or a newcomer with moderate drawing skills, sketches are great for relaying an impression of your design ideas but should you […]
5 Challenges Fashion Entrepreneurs Overlook

Here are 5 categories of challenges in fashion business that fashion entrepreneurs fail to focus on at the start of a new brand/business/product launch. This article will help you figure out what you can do about these challenges.
What are the Basic Costs Associated with Sample Development?

What is sample development and how to work out & plan how much money you will need for sample development if you are just starting out?
Consumer Wants Personalisation: What Does it Mean for Businesses?

Can a business fulfil every demand put across by consumers? These days consumers have become creators as well as critics and it has put a good load on small businesses. Find out what consumer personalisation means for businesses.
Fashion Job Opportunities for Students After Graduation

Are the students learning anything valuable (i.e., updated) in terms of the real-world fashion jobs? After graduation, students are not left with enough opportunities thus, leading to designers only. Here we explore more fashion jobs opportunities after graduation.
How to Protect Your Designs From Being Copied

Individuals and brands don’t mind copying a design, if they think they can get away with it. In this article, we cover various ways in which you can stop getting plagiarised and protect your future designs.
In How Many Varieties, Colours & Sizes Should You Launch Your Brand?

Ever wondered what size should you launch your brand in? S, M, L and in what quantities? What about colourways? Should you include more styles in each? Here is your answer.
The Couture of the Present and Future: How it is Surviving

In the past, we have covered haute couture designers through the ages: 1900’s-1950’s. In this post, we will cover the present day haute couture designers, how it is surviving, who is buying it and how it has changed.
How to Get the Best Out of Your Mentor [and grow your business]

We all need mentors in some point in our lives. Whether it’s our own business or a 9 to 5 job, these top tips will definitely help us find the right mentors for us and get the best out of them.
Haute Couture Designers Through The Ages: The 1930’s-50’s (Part 2)

The “couture” of the past – what it means – history and origins, who did it, who bought it, couture techniques that make couture – couture. Here we talk about the period 1930s-50s part 2
Haute Couture Designers Through The Ages: The 1930’s-50’s (Part 1)

The “couture” of the past – what it means – history and origins, who did it, who bought it, couture techniques that make couture – couture. Here we talk about the period 1930s-50s.
The Fragmentation of Retail: What is happening now?

Let’s look at the factors contributing to the fragmentation of retail.
What Should be Your First Step to Start a Fashion Brand?

Have an idea and don’t know what to do with it, where to begin and what is important to know? Read the answer below
Are Retail Stores Dead or Are They Getting Redesigned?

Is the Retail vs E-commerce battle, really worth fighting over? Can’t they both live in harmony and both the worlds coexist?
Read the author’s view in this article.
Silent Goods: Bravery in the face of adversity

Silent Goods is a brand that asks the question – Is it really possible to go against the grain and to create a fledgeling, sustainable and transparent brand that’s distributed through online sales only?
Made My Wardrobe – From Passion to Business With Lydia Higginson

I “made my wardrobe” is not something you often hear someone say. There are many motivations behind the decisions to make your own clothes. Utelier meets Lydia Higginson who did just that and in the process turned her passion into a business.
7 Eco-Friendly Practices Every Small Fashion Business Can Do

Brands with any integrity have been thinking of ways to build their businesses with a sustainable advantage for a while now. Below are 7 Eco-friendly practices that a fashion business can do to contribute to sustainability in the fashion industry.
How to Finance a Fashion Business?

Knowing how to finance a fashion business is one of the essential requirements for staying in business. Read our 5 top tips on how to find funds for your fashion idea.
How to Work with Fashion Manufacturing Companies as a Startup

Working with fashion manufacturing companies is easy if you know and follow the few simple do’s and don’t do’s most entrepreneur learn the hard way. Don’t be one of them – read this and get a start on the right track.
What Clothing Manufacturers Want Fashion Startups to Know

It has never been so easy or so hard to start a fashion brand. Read what clothing manufacturers wish fashion startups do less of and how to best present yourself to suppliers if you want to work with them.
9 Top Tips to Get the Best Out of Your Pattern Cutter

How to get the best out of your pattern cutter should be at the forefront of your mind if you’re about to embark on developing a fashion range. Learn how to prepare for your meeting.
How to Best Connect with Retail Buyers and Stay in Touch?

One of the hardest things for a fashion brand is to know how to connect with retail buyers and stay in touch with them continuously.
I Can’t Sketch! How Can I Communicate My Ideas on Paper?

You don’t have to be Karl Lagerfeld to launch your brand. Learning how to communicate your designs and draw is just a skill that, with practice, can be acquired and improved on.
Where Should I Make My First Proto Sample?
A beginner or an experienced professional, everyone needs to know the best way to make their first proto sample.
The Fashion Switch: The New Rules of Fashion Business

The Fashion Switch is an essential easy read for anyone interested to start a fashion business or even for those who are already in the industry. It is insightful and practical, peppered with case studies and examples of business mistakes or wins.
How to Start a Handbag Line?

To start a handbag line in such a competitive retail marketplace is a brave endeavour and definitely not for the faint-hearted. All aspects of its development need to work harmoniously in order to create a ‘perfect storm’.
Should I Have a Pattern Ready Before I Contact a Factory?
If you are a beginner, how will you create your pattern before even fixing a factory in the first place? Read to know how.
7 Top Tips How to Avoid Manufacturing Drama During the Chinese New Year

The Chinese textile manufacturing industry is one of the world’s biggest apparel exporters to the west. But their Chinese new year celebrations can affect negatively your fashion business. Read and learn how to avoid this from happening.
What is a Fashion Lookbook and How to Create one?

Once you have perfected the design process, product development and sample making, your marketing should begin in earnest. Catching the eye of important buyers, press and potential customers can be done in many ways but the most effective is to send out a fashion lookbook.
How to Make the Best of Minimum Order Quantity (MOQ)?

MOQ (Minimum Order Quantity) is a requirement of factories – the lowest quantity of a certain product that a supplier is willing to produce.
Haute Couture Designers Through the Ages: The 1920’s

Unlike ready-to-wear which is about predicting the future, couture while expensive is an altogether more relaxed affair. The point of haute couture fashion is that it symbolizes the present for future generations to learn about the past. Learn the history here.
How Cutting Fabric for Production can Bring You Savings

Cutting fabric for production is a skill seasoned professionals know about and use as a way to make savings. Scaling up from sampling to production is a huge leap in regards to fabric and trimmings consumption.
How to Make a Handbag When Your Background Isn’t in Fashion

Every day newcomers enter the fashion industry. While they may bring new ideas and enthusiasm, their lack of knowledge of how the industry works, development and sourcing know-how and process often leaves them exhausted and with depleted funds.
Haute Couture Designers Though the Ages: The 1900s

Every industry has its own way of expressing technical might and glamour. Car manufacturers have supercars that showcase their expertise. In fashion – it is the Haute Couture collections that showcase a designer’s most outrageous ideas, where budget is no limit to ambition and clients are few and far between. This is Part 1 of […]
What are Fashion Trend Forecasting Agencies?

Fashion trend forecasting agencies are the “archaeologists of the future”. Read what they do, how they do it and why are they important.
What Makes a Perfect Fitting Session?

Read on to learn what makes a perfect fitting session and what you must ensure you have in place if you do not want to waste time and money.
Fashion Product Testing: Basic Tests you Should be Doing Regularly
Fashion product testing Furthermore enables the reduction of risks such as product recalls, helps protect your brand and gain the trust of the consumer. Learn what are the basic tests you should perform for your product.
How Denim Manufacturing Impacts the Environment

If you are a denim-wearing eco-warrior then perhaps you are more fashion and less eco-conscious! Read below and get the basics of why the current denim manufacturing has a negative environmental impact.
The Importance of Fashion Care Instruction Cards

Care instruction cards are an excellent way to communicate your brand values and educate your customer about your product, especially if your products are handmade or use any specialist materials.
17 Timeless Must Watch Fashion Film Titles to Inspire You

Films – be it documentaries, short or feature-length movies hold the power to make us laugh or cry in equal measures; they can educate and above all – inspire us to dream.
11 Top Tips for Working with Indian Manufacturers

Working with Indian manufacturers offshore is a good option for any growing fashion brand looking to improve margin, but before you embark, consider these wise words and the benefit of others experiences.
3 Tips to Make a Perfect Garment Sample

Making a perfect garment sample good enough for the factory to follow through to production, can be approached in three ways. Whichever way you choose, your final outcome is to produce items to a very high standard so that they can be used by a factory as a template for your production.
Fashion Insider Tips for Sourcing Fabric Efficiently

Sourcing fabric for new fashion collections is one of the most exciting aspects of running a fashion label. Learn how to do it better with our top tips.
The One Thing by Gary Keller

The One Thing by Gary Keller is an insightful book about eliminating what you want less and including what you want more. The One Thing reaches to a near about perfection in delivering what it promises – mastering ONE THING.
Can the use of alternative textiles be the answer to sustainable fashion?

Introducing alternative textiles is just one and a relatively small step in creating a sustainable environment and it may be the answer to the sustainable fashion quest.
What is a Fashion Buying Agency? – By Ayushi Nath

Foreign brands that work in Asia often do so with the help of buying agencies. Ayushi Nath, a fashion designer at Impulse buying agency based in India, shares the inner working of a design and manufacturing agency.
What is a Fashion Mood Board and how to create one?

At the start of every new season, fashion designers sift through their research and distil the essence of it into what is commonly referred to as “fashion moodboard”. A visual diary of details and inspirations that will later serve as a guideline and constant source of further inspiration while finalising the new collection.
Top 5 best fashion inspiration sources for designers

Ever wondered how top fashion designers manage to create multiple collections per year? Season after season, year after year, seemingly never running out of ideas. Fashion inspiration is behind it all.
A fashionista’s guide to the basics of Pattern Grading
Creating pattern for garments is exciting, but the art of pattern grading is a skill not many posses. Yet the mass market relies on it for scale.
The Basics of How to Start a Fashion Business

Starting your own brand can be the most exciting thing in the world. Designing your dream line and the prestige of selling your collections in renowned stores are surely very enticing. However, the reality of setting up shop will be something entirely different to your initial perceived idea. Read up and find out what is vitally important to know before you start.
The War of Art by Steven Pressfield

A succinct, engaging, and practical guide for succeeding in any creative sphere, The War of Art is nothing less than Sun-Tzu for the soul. Always wanted to write, start your own business, or paint? What is stopping you?
The vital importance of fashion archives for fashion brands

Fashion archives allow new designers to delve into a past that was very different to the present. It can be used in order to gain some insight into the brands DNA.
Atlas Shrugged, by Ayn Rand

Atlas Shrugged is a black and white story of characters that are destroying themselves for reasons that will baffle you. It is not a story for the faint-hearted.
Top tips on growing your business exposure with Pinterest

Pinterest is a social media platform of choice for brands, due to the ability to curate visual content and drive traffic to the brands’ commercial channels.
What is “Just In Time” Manufacturing?

In the 1940s the Toyota Motor Company pioneered a type of manufacturing called “Just-In-Time.” Its objective was to eliminate waste, inconsistencies, and unreasonable requirements from the production process, thus resulting in improved productivity. Simply put, it meant making only what was needed, when it was needed, and in the amount needed.
Finding a Pattern Cutter can be easy if you know what to look for

Finding the right pattern cutter for your needs can be a daunting experience. Often people in the industry say that good pattern cutters are like gold dust. Knowing how to find the right one can be hard or easy if you know how to look for one. Read on to learn what to look out for.
What is a Garment Tech in the fashion industry?

The mysterious person who liaises with designers, adapts designs to suit production methods, sources fabrics, and accessories, undertakes quality evaluations of materials and responds to product queries, including complaints, from wholesalers and customers is the Garment Tech.
The Ultimate “How To” Guide to Working With Denim Fabric

Did you know that it takes 10,000 litres of water to make one pair of jeans! But please don’t let that put you off working with denim. It’s one of the most distinctive, hardwearing and versatile fabrics available for use in the fashion industry.
How to Win Friends and Influence People, by Dale Carnegie

Ask any successful entrepreneur what book has helped and influenced them most, and chances are most will mention this perennial favourite. Dale Carnegie’s best seller, written in 1937 is timeless and as relevant as ever before, even in today’s competitive world.
What is “Pantone colour” and why is it important in fashion design?

The Pantone Matching System (PMS) is widely sued in the Fashion industry and was created to allow designers of any discipline to ‘colour match’ specific colours when a design enters production stage—regardless of the equipment used to produce the colour.
Fashion Photography Basics

For all the energy you spend designing and creating, it’s a shame if a photograph fails to capture your effort when you put your pieces out into the world. This crash course in Fashion photography will definitely help you master the art, beautifully.
9 Tips To Help You Find The Right Fashion Manufacturer
Finding the right fashion manufacturer for your idea is not an easy task at the best of times. In fact, entering the world of manufacturing can be a heady mix of initial excitement followed by angst, unnecessary expense, and frustration.
Why fashion manufacturing locally can open a world of possibility for new brands

Fashion manufacturing locally is not a new concept. It has been done by brands large and small for as long as manufacturing has existed. But with advances in technology that helped make the world more reachable, many have tried their fortunes far afield hoping to improve prices, leadtimes or quality.
Aim for “good” rather than “perfection”

When you run a business, you cannot afford to chase “perfection”. Commercial thinking must be exercised, deadlines respected and the business needs put first.
Changing Dynamics of Garment Manufacturing in India

India based Meenal Malhotra caught the fashion bug post her MBA stint in Finance and Marketing. After gaining some insights into the fashion industry whilst working with Masaba, the well-known fashion designer from India, she decided to set up a factory of her own – R and M Enterprises.
Everything You Need To Know About The Sample Making Process

Embarking on garment sample making is one of the most exciting and satisfying parts of the design process. Bringing your ideas to life in the form of a tangible product is the icing on the cake after months of designing, fabric sourcing and pattern cutting.
5 No-Brainer Tips to Increase Brand Value
People buy most products, especially luxury goods because of branding. This one, short, two-syllable word is vital for successful fashion businesses.
3 tips for launching a website in no time and on a budget

Launching a website is no longer a choice for a business. Regardless of the size, industry and location – not having a website is like not having a name. So what can you do on a budget? A lot more than you might think is the answer.
The Freelance Fashion Designer’s Handbook

The Freelance Fashion Designer’s Handbook is your essential guide on how to work for yourself and take control of your career.
Pre-Suasion: A Revolutionary Way to Influence and Persuade

Pre-Suasion an essential tool for anyone serious about science-based business strategies.
Simon Sinek: “Start With Why”

Simon Sinek is leading a movement to build a world in which the vast majority of us are inspired by the work we do.
The Importance of the Pattern Cutter in Fashion
Every successful fashion brand has a hidden pattern cutter in the background. Read why it is so important to have one and the types of pattern cutting available to designers today.
7 Most Common Fashion Business Mistakes

Fashion business mistakes are easy to make and hard to correct. Seemingly small, they can fast lead to the death of your business in a matter of months or less. We look at what they are and how to avoid them.
Business Crowdfunding for Fashion Brands

Many emerging designers are making the decision to crowdfund their projects – a great post-recession fundraiser – to create a product that they love and know their target consumers will also love, and buy.
6 Productivity Hacks to Save Time and Money

For any entrepreneur, time is of short supply and of great demand. So here are 6 simple productivity hacks that may help a little manage your time better.
21 tips on how to launch a successful Kickstarter campaign

Crowdfunding has become one of the key ways in which small businesses can raise essentials funds to either start up or launch a new area of business or project. While you may not raise as much as money as you would by using an investor, crowdfunding means not parting with any equity.
5 tested tips for finding the right fashion manufacturer

Finding a good manufacturer is not as tricky as many believe it to be. Like with any first business meeting, you need to go prepared and armed with clear information about who you are, what your business is about, where you want to go, and what you need out of this meeting.
5 Reasons You Need a Business Mentor

Having a mentor is one of the things in life that those that most need it – either don’t know about it or don’t know how to find one; and those that we would consider as least needing one i.e. they are already successful – almost without fail currently have or have had one in the past, because they know and understand the value a good advisor brings.
Simple Fashion Branding Basics for Start-Ups

Once upon a time, not that long ago, the word “logo” was synonymous to “brand”. Fast forward a couple of decades and today a “logo” is merely a shadow of a “brand”, but nowhere near what a “brand” is. Yet – not many people seem to make the distinction and realise this. Especially start ups.
How to design a commercially strong fashion collection

Launching and running a product based fashion brand more often than not revolves around the creation of collections. The quality of these collections and the consistency of that quality and presentation, is often what sets successful brands from the rest.
How to Network Even If You Hate It

Being in the fashion industry means that you have to schmooze (read: network as a professional) at events. But being a fashion business owner means that you have to effectively network with a range of people, at a number of different events.
Finding Investors for Your Fashion Business

If you have decided that finding an investor for your fashion business is the best option for you, here is some advice on how to prepare yourself to find the right one; whether you’re looking for a venture capitalist, an angel investor, a super-angel or a growth investor.
4 Top Tips for Working With Bloggers

Working with bloggers has become a mainstream modus operandi for anyone looking to gain media exposure for their brand. Here are some tips and tricks.
5 Top Tips for a Successful Pop-Up Shop

Have you thought about running a pop-up shop to sell your products? If you are, there are many points to consider to ensure that your brand’s message is translated to your target audience.
Design and Product Development

It is no secret that the fashion industry is predominantly a product-based industry. Success is often underpinned by great design, strong product and well-structured collections. Learn how to translate your ideas correctly into the products that you want.
The Best Ways to Allocate Your Budget

Rarely does a new business start with enough money to last until a profit is turned. It might happen in the movies, but what happens in real life – more often than not – is that you start spending some or all of the capital you have raised.
5 tips on how to work with a manufacturing supplier

Here are some tips on how to work with a manufacturing supplier.
The Do’s & Don’ts of Communicating with Factories

How frustrating is it when you contact factories or suppliers and get no response? Here are the Do’s and Don’ts of communicating with factories so that you get better results.
Financing a Fashion Business: Start Up Guide to Funding your Business

Financing a fashion business is essential for success. Some businesses don’t require large capital at the start. Sadly for most fashion businesses. Learn how to fund your fashion start up.
Equity vs. Debt

Financing a business can come in many forms, but regardless of how you raise cash, more often than not you will be dealing with equity or debt. So, let’s explain what they are, and how they can work for or against us.
6 things to remember when launching a fashion business

Well done! You’re about to launch your fashion business, there is so much you need to focus on and your mind is busy with endless to-do lists. We’ve compiled the key things that you need to bear in mind to give you clarity, and act efficiently and effectively.
3 Top Tips for Better Fashion Product Pricing

Fashion product pricing is essential, yet tricky to get right. To make your fashion business work, one of the key things you must do is make a profit. Learn what is required in order to get the price right outright.
MYB Textiles Mill Video
[vc_row][vc_column] [bs-embed url=”https://youtu.be/rxkWp6s69uc” title=”Video / Embed” show_title=”1″ icon=”” heading_color=”” heading_style=”default” bs-show-desktop=”1″ bs-show-tablet=”1″ bs-show-phone=”1″ bs-text-color-scheme=”” css=”” custom-css-class=”” custom-id=””] [/vc_column][/vc_row][vc_row][vc_column][vc_column_text] Over the years MYB Textiles have invested heavily in developing and modernising the production techniques involved in creating Scottish and Madras lace. In this video, they guide us through the history of the company as well as […]
How To Write A Fashion Press Release

A well-written and curated press release is a sure way to get into the inboxes of key fashion editors. If executed well, it may secure you much desired editorial coverage and publicity.
Diane von Furstenberg: The Woman I Wanted to Be

This is Diane von Furstenberg’s personal memoir and it is raw. It may seem like an explanation of who she is, why she works hard and the pride she takes in her profession. But, it goes deeper than that.
Business Planning for Success

Imagine this – you have a great idea, you want to start your own business and everyone you tell is supportive and encouraging, and then they tell you firmly in a non-negotiable tone of voice, “You MUST write a business plan!”
What To Look For In A Manufacturing Partner

One of the challenges most often faced and talked about in fashion is the delicate matter of finding a manufacturer – the right manufacturer for you and your brand.
Build A Fashion Website – The Legal Steps, Part 2

Following on from last week’s Building A Website – The Legal Steps, Part 1, where Tahir Basheer offered advice on finding a domain name, your website content and data, this week he concludes the two part-series.
Top Tips For Creating Your Own Eyewear Line

If you’re considering making an eyewear line, eyewear designer Sandra Battistel shares her wealth of advice and experience with these top tips.
The Registered Trademark and Your Brand

Brand logos will be gracing the silhouettes of bloggers and many other FROW members this weekend at the London Fashion Week shows – and lusted after by many other fashionistas in attendance.
There is a lot more to branding than simply a product being recognisable to others, as Tahir Basheer – an Industry member specialising in fashion and media law for leading London-based law firm, Sheridans – explains.
The Benefits of Crowdfunding Fashion Start-Ups

We were fortunate enough to engage with the motivational force that is Rose Spinelli, a crowdfunding consultant based in America. She has been named among the ‘Top 100 Thought Leaders in Crowdfunding Today’.
The Pre-Business Plan

Working in fashion is often not for the faint hearted. But starting your own business, your own brand – as some would say – that’s a different ball game.
The Glitter Plan by Pamela Skaist-Levy & Gela Nash-Taylor

The Glitter Plan is a great book and a must read for anyone thinking of starting their own fashion label.
Fashion Insiders Launches The Toolkit Series

Over the coming months, in addition to our regular interviews with our network of designers and manufacturers, and industry news scoops, Insider will introduce a regular series of articles on how to set up your own new fashion business.
5 Not-So-New Business Resolutions

Take the root of the word more literally and create a movement to resolve your business. There is hope and it is not too late, so, recalibrate and let’s recalculate your 2015 journey.
Multi-Cultural Business Challenges

The fashion industry is multi-national, multi-cultural and multilingual, with the latter approached in a technical manner and interpretation often ignored.
Setting the Table by Danny Meyer

Ever wondered if you can be a good ‘boss’ without being mean and hated? Do you fall asleep at the thought of a business book? Love food and a good ‘How I Made It’ story? If your answers are yes, yes and yes – you are in luck, there is a book that ticks all three boxes.
Top 10 Tips for Successful Public Relations: Part Two

It is a truth universally acknowledged that the world of fashion has never before been as competitive as it is today. To start with an idea is easy in comparison to turning that acorn of an idea into a successful business. There are many prerequisites in the recipe for success but one of the main ingredients is PR. Here are our top tips on how to market your brand.
Top 10 Tips for Successful PR: Part One

There are many prerequisites in the recipe for success but one of the main ingredients is PR. While the world of press has also evolved and changed, few things however still remain relevant and necessary to do, in order to garner attention. Here is our top tips
10 Top Tips – How to Protect Your Brand

With the help of our expert from Sheridans Media lawyers we bring you the top 10 tips of how to protect your brand.
Top 10 Employment Law Myths

In fashion we are often surrounded by myths and hear-say information. We spoke to lawyers from Sheridans Employment Group to demistify some of these myths and more…
The Questionable Future of Fashion Wholesale?

Over the last couple of decades, as the online shopping has steadily increased at a fast and furious pace, countless boutiques closed their doors and larger department stores sales suffered – many wonder what is the future of fashion wholesale?
What is sustainable fashion and is fashion sustainable?

Now, more than ever, we should be thinking about sustainable fashion. But what is sustainable fashion? And is fashion sustainable?
“Made in Britain” – to be or not to be?

With Brexit looming over us and the louder voiced opinions and encouragements to keep as much as possible “Made in Britain”, we look at what that means.
The Impossible Choice: Fast Fashion vs Slow Fashion

Making a choice between fast fashion vs slow fashion may seem like an obvious choice, yet it is not an easy choice for many to make. One has moral implications while the other is more practical and economical. So what is it to be?
Getting Trade Press for Your Fashion Business
The editor of U Magazine attended a talk at last week’s International Jewellery London show, on the ways in which fashion brands and designers could work effectively with the trade press.
The Power of Fashion Collaboration

The landscape of fashion has become increasingly democratized, and the formula of offering limited edition pieces designed in collaboration with another brand or person has proven to be extraordinarily lucrative.
Fashion Business Notes from India

Team Fashion Insiders swaps continents and goes to India for a week packed with exploring a new market, forging new contacts, connections and absorbing new experiences and lessons.
Made in England – Why Buy British?
Fashion industry professionals including small business owners, students and representatives from UK Trade & Investment (UKTI) and the UK Fashion & Textile Association (UKFT) were among the crowd at the sell-out event in Manchester yesterday evening (Wednesday 29 July)
The Changing Face of the Fashion Industry

Years ago, the seasonal selling formula for a designer was pretty simple and straight forward. Fast forward to 2017 and this no longer is the case.
Garment Manufacturer Plus Samples Ltd.

Utelier’s visit to a NW London factory specialising in high end (ready to wear) ladieswear soft separates garment pattern development, grading, sampling and small run production.
What a Manufacturer of Leathergoods Wants You to Know

BeTangible is a leathergoods and sample-making manufacturer, based in Ubrique, Spain, co-founded by ex-colleagues Pepe Montiel and Manuel Millan. They met during their careers at a larger fashion manufacturer, and both had grown tired of certain practices.
I Can Make Shoes: the Business of Handmade Footwear

Amanda Overs, 29, is the founder of the innovative fashion business, I Can Make Shoes. Over the past five years, people from any background have been able to join a class to make a pair of shoes from scratch that they can keep.
What happens during an intellectual property battle?

There are so many things that you prepare yourself for when launching your fashion business, but no matter how ‘ready’ you are, receiving a letter that could threaten your business, and an intellectual property (IP) battle with a big brand would shock anyone. So what happens when a fashion start-up is told that the unique name created for their brand, is an infringement on a big brand’s trademark? It happened to Michaela Anderson last year, and she shared her journey with us to inform others.
ACID: Anti Copying In Design

Anti Copying In Design (ACID) is a trade organisation set up by designers for designers & manufacturers, to help them protect their intellectual property.
Celebrity Gifting: A Sound Marketing Strategy?

Imagine making one of your products: designing it, sourcing materials, manufacturing it and then putting it through vigorous quality control measures, and then giving it to someone for free.
UK Garment Factory Workers Under Threat

It’s important to remember on this Fashion Revolution Day and two-year anniversary of the Rana Plaza disaster that unethical treatment of factory workers lives on, and not just in Asian countries.
What We Didn’t Know About Leather

Hannah Stewart, a Product Account Manager at a London-based fashion company woke up at 5.30am recently, to travel two and a half hours from her London home to Northampton. She was attending the BLC Leather Technology Centre’s ‘Understanding Leather Course’, led by Barry Wood – a leather technician who has worked in the fashion industry for over 25 years.
Natasha Hulse – The Beauty of Print Textiles

Natasha Hulse is the owner of Natasha LG Hulse Design and a graduate of Chelsea College of Art and Design. She specialises in print design, and her womenswear collections feature bold colours and flowing, yet well-structured garments.
Bespoke Shoemaker John Lobb Set to Grow

One of the most respected welted shoemakers John Lobb, has been producing shoes since the mid-19th Century. Now, this Northampton-based £25m business is set to grow.
MYB Textiles – The Modern Lace Makers

Lace has long been a treasured decorative element for fashion, interiors and hosiery. Yet when we talk about lace and the manufacture and making of it, we don’t usually think of lace and British manufacture in the same sentence. But surprisingly, we should! MYB Textiles based in Scotland is a lace manufacturer success story worth sharing and we find out exactly why from Wendy Murray from MYB Textiles.
“No Comment” – The Art of Being Hermes

As anyone who knows or follows the luxury goods industry will tell you – there are luxury goods companies and then – there is Hermes. The family owned leather goods maker is a true champion of “the art of craft”. They continuously find new ways to educate and showcase what true craftsmanship means be it through pop up exhibitions, store demonstrations or videos. The latest new initiative paying respect to the true unsung heros behind the brand are a series of videos simple titled “No Comment”.
Shop Til’ You Pop

Pop-up shops are taking over the retail world but what exactly is a shop that pops up? Pop-up shops are temporary stores at a designated venue, the purpose of which is to attract the consumer with something exclusive and exciting. Layla Webster delves to find out more.